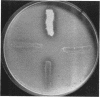
1471

Abstract
Lanyi, Janos K. (Stanford University School of Medicine, Palo Alto, Calif.), and Joshua Lederberg. Fluorescent method for the detection of excreted ribonuclease around bacterial colonies. J. Bacteriol. 92:1469–1472. 1966.—A test for the release of extracellular ribonuclease by Bacillus subtilis colonles was developed. The method consists of incorporating acridine orange and ribonucleic acid into nutrient agar plates and viewing the grown bacterial colonies under ultraviolet light. Regions of ribonuclease secretion appear as dark halos around the colonies on a green fluorescent background. The theoretical basis and the utility of this test are discussed.
Full text
PDF



Images in this article
Selected References
These references are in PubMed. This may not be the complete list of references from this article.
- Berry S. A., Campbell J. N. A diffusion plate technique for the detection of polynucleotide depolymerase and phosphatase activity. Biochim Biophys Acta. 1965 Jun 22;99(3):566–569. doi: 10.1016/s0926-6593(65)80216-8. [DOI] [PubMed] [Google Scholar]
- Bradley D. F., Wolf M. K. AGGREGATION OF DYES BOUND TO POLYANIONS. Proc Natl Acad Sci U S A. 1959 Jul;45(7):944–952. doi: 10.1073/pnas.45.7.944. [DOI] [PMC free article] [PubMed] [Google Scholar]
- Eaves G. N., Jeffries C. D. ISOLATION AND PROPERTIES OF AN EXOCELLULAR NUCLEASE OF SERRATIA MARCESCENS. J Bacteriol. 1963 Feb;85(2):273–278. doi: 10.1128/jb.85.2.273-278.1963. [DOI] [PMC free article] [PubMed] [Google Scholar]
- JEFFRIES C. D., HOLTMAN D. F., GUSE D. G. Rapid method for determining the activity of microorganisms on nucleic acids. J Bacteriol. 1957 Apr;73(4):590–591. doi: 10.1128/jb.73.4.590-591.1957. [DOI] [PMC free article] [PubMed] [Google Scholar]
- Kerr I. M., Pratt E. A., Lehman I. R. Exonucleolytic degradation of high-molecular-weight DNA and RNA to nucleoside 3'-phosphates by a nuclease from B. subtilis. Biochem Biophys Res Commun. 1965 Jul 12;20(2):154–162. doi: 10.1016/0006-291x(65)90339-6. [DOI] [PubMed] [Google Scholar]
- LEITH J. D., Jr ACRIDINE ORANGE AND ACRIFLAVIN INHIBIT DEOXYRIBONUCLEASE ACTION. Biochim Biophys Acta. 1963 Aug 20;72:643–644. [PubMed] [Google Scholar]
- LERMAN L. S. The structure of the DNA-acridine complex. Proc Natl Acad Sci U S A. 1963 Jan 15;49:94–102. doi: 10.1073/pnas.49.1.94. [DOI] [PMC free article] [PubMed] [Google Scholar]
- NAKAI M., MINAMI Z., YAMAZAKI T., TSUGITA A. STUDIES ON THE NUCLEASES OF A STRAIN OF BACILLUS SUBTILIS. J Biochem. 1965 Jan;57:96–99. doi: 10.1093/oxfordjournals.jbchem.a128063. [DOI] [PubMed] [Google Scholar]
- Rothberg N. W., Swartz M. N. Extracellular Deoxyribonucleases in Members of the Family Enterobacteriaceae. J Bacteriol. 1965 Jul;90(1):294–295. doi: 10.1128/jb.90.1.294-295.1965. [DOI] [PMC free article] [PubMed] [Google Scholar]
- STREITFELD M. M., HOFFMANN E. M., JANKLOW H. M. Evaluation of extracellular deoxyribonuclease activity in Pseudomonas. J Bacteriol. 1962 Jul;84:77–80. doi: 10.1128/jb.84.1.77-80.1962. [DOI] [PMC free article] [PubMed] [Google Scholar]
- Spizizen J. TRANSFORMATION OF BIOCHEMICALLY DEFICIENT STRAINS OF BACILLUS SUBTILIS BY DEOXYRIBONUCLEATE. Proc Natl Acad Sci U S A. 1958 Oct 15;44(10):1072–1078. doi: 10.1073/pnas.44.10.1072. [DOI] [PMC free article] [PubMed] [Google Scholar]
- WANNAMAKER L. W. The differentiation of three distinct desoxyrlbonucleases of group A Streptococci. J Exp Med. 1958 Jun 1;107(6):797–812. doi: 10.1084/jem.107.6.797. [DOI] [PMC free article] [PubMed] [Google Scholar]